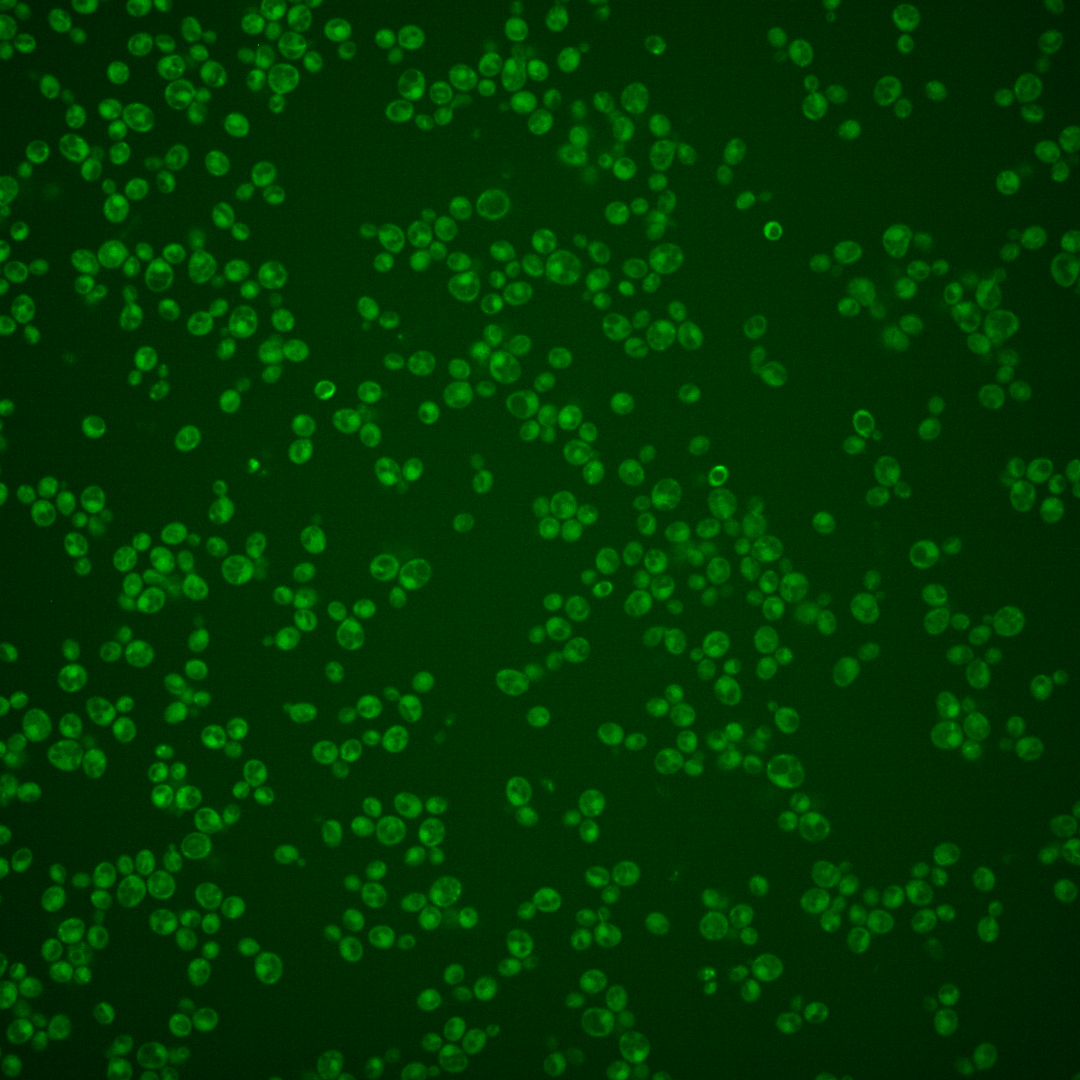
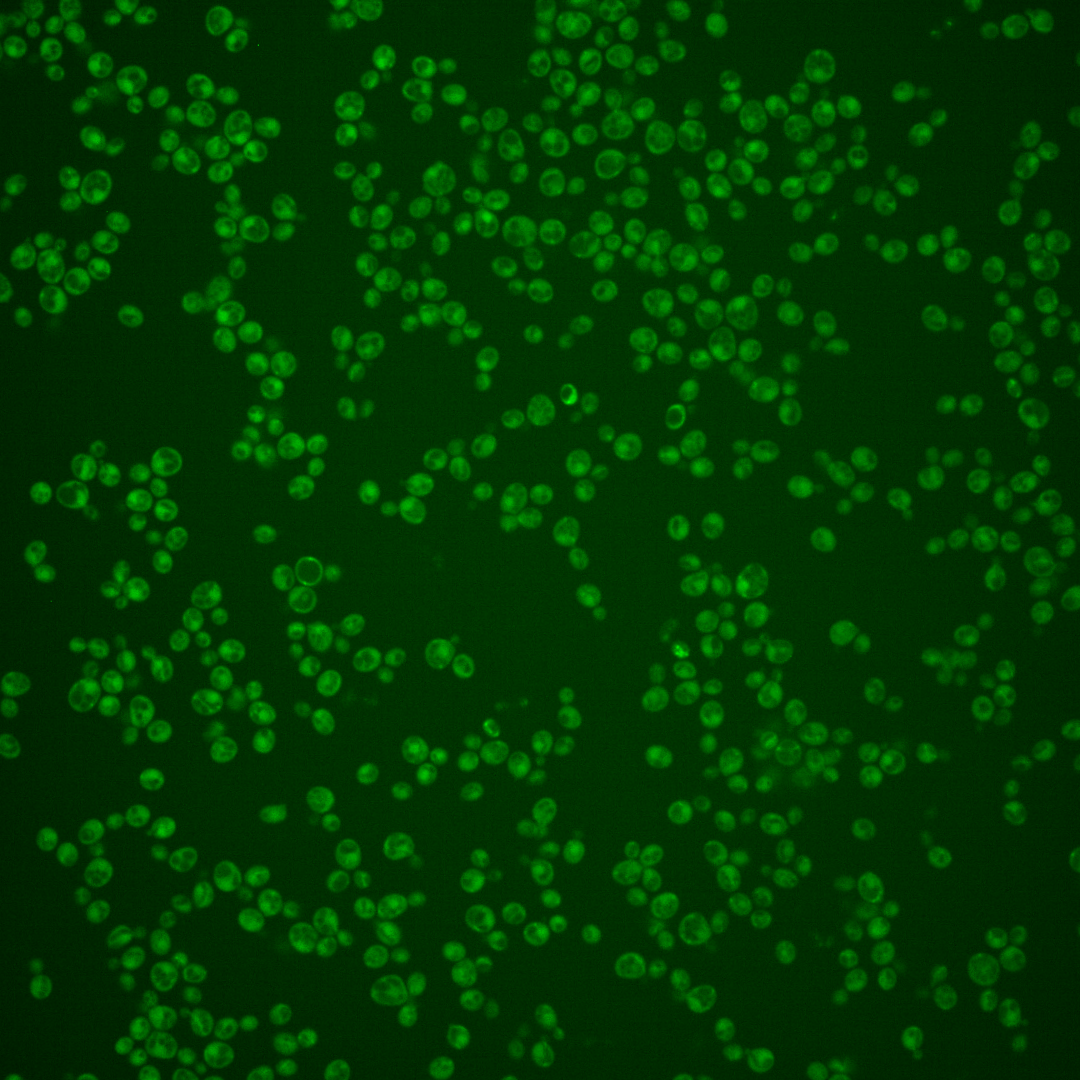
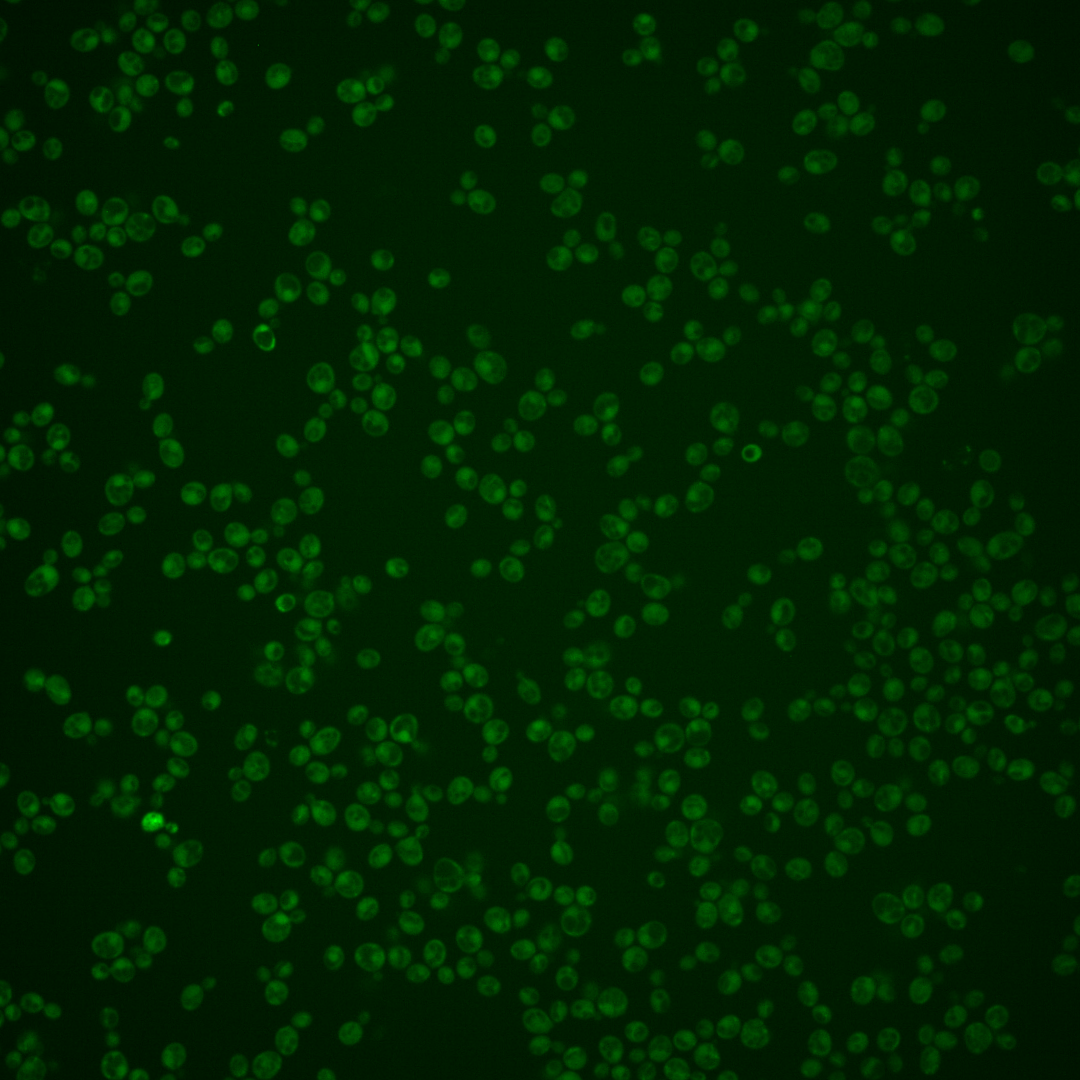

| Standard name | |
|---|---|
| Human Ortholog | |
| Description | Protein of unknown function; inhibits haploid invasive growth when overexpressed; synthetically lethal with phospholipase C (PLC1); expression induced by mild heat-stress on a non-fermentable carbon source, upon entry into stationary phase and upon nitrogen deprivation; repressed by inosine and choline in an Opi1p-dependent manner; highly conserved from bacteria to human; Memo, the human homolog, is an ErbB2 interacting protein with an essential function in cell motility |
Micrographs




















































































Sub-cellular Localization
Yeast GFP Assignment
Protein Abundance
Localization Change
External localization resources
| ensLOC | DeepLoc | |||||||||||||||||||||||
|---|---|---|---|---|---|---|---|---|---|---|---|---|---|---|---|---|---|---|---|---|---|---|---|---|
| Localization | WT1 | WT2 | WT3 | RAP60 | RAP140 | RAP220 | RAP300 | RAP380 | RAP460 | RAP540 | RAP620 | RAP700 | HU80 | HU120 | HU160 | rpd3Δ_1 | rpd3Δ_2 | rpd3Δ_3 | WT1 | WT2 | WT3 | AF100 | AF140 | AF180 |
| Cortical Patches | 0 | 0 | 0 | 0 | 0 | 0 | 0 | 0 | 0 | 0 | 0 | 0 | 1 | 0 | 0 | 0 | 1 | 1 | 1 | 2 | 3 | 2 | 5 | 3 |
| Bud | 1 | 0 | 0 | 0 | 0 | 1 | 11 | 7 | 11 | 5 | 11 | 9 | 0 | 0 | 1 | 0 | 0 | 2 | 0 | 2 | 2 | 1 | 14 | 8 |
| Bud Neck | 0 | 0 | 3 | 7 | 8 | 2 | 8 | 6 | 3 | 8 | 5 | 6 | 2 | 1 | 2 | 0 | 0 | 0 | 0 | 1 | 0 | 0 | 4 | 2 |
| Bud Site | 0 | 0 | 0 | 0 | 0 | 0 | 1 | 1 | 2 | 2 | 2 | 2 | 0 | 0 | 0 | 0 | 0 | 0 | – | – | – | – | – | – |
| Cell Periphery | 2 | 1 | 1 | 2 | 0 | 2 | 0 | 1 | 0 | 1 | 0 | 0 | 1 | 1 | 1 | 0 | 0 | 0 | 0 | 0 | 2 | 1 | 2 | 1 |
| Cytoplasm | 120 | 86 | 238 | 240 | 272 | 276 | 309 | 259 | 192 | 197 | 139 | 145 | 229 | 314 | 374 | 22 | 14 | 15 | 108 | 71 | 152 | 141 | 223 | 208 |
| Endoplasmic Reticulum | 2 | 1 | 2 | 0 | 0 | 0 | 0 | 1 | 0 | 0 | 0 | 0 | 0 | 0 | 0 | 12 | 3 | 2 | 1 | 0 | 3 | 0 | 1 | 1 |
| Endosome | 0 | 2 | 0 | 0 | 2 | 1 | 0 | 1 | 0 | 0 | 0 | 0 | 0 | 0 | 2 | 7 | 2 | 5 | 0 | 4 | 6 | 0 | 2 | 1 |
| Golgi | 0 | 0 | 0 | 0 | 1 | 0 | 0 | 0 | 0 | 0 | 0 | 0 | 0 | 1 | 0 | 0 | 1 | 0 | 0 | 1 | 0 | 0 | 1 | 0 |
| Mitochondria | 27 | 5 | 0 | 5 | 10 | 59 | 127 | 83 | 151 | 109 | 118 | 111 | 0 | 1 | 0 | 1 | 5 | 4 | 18 | 24 | 36 | 10 | 9 | 12 |
| Nucleus | 0 | 2 | 0 | 11 | 27 | 32 | 49 | 55 | 34 | 37 | 34 | 30 | 2 | 1 | 2 | 94 | 83 | 58 | 0 | 0 | 0 | 0 | 0 | 0 |
| Nuclear Periphery | 0 | 0 | 0 | 0 | 0 | 0 | 0 | 0 | 0 | 0 | 0 | 0 | 0 | 0 | 0 | 0 | 0 | 0 | 0 | 0 | 1 | 0 | 0 | 2 |
| Nucleolus | 0 | 0 | 0 | 2 | 0 | 0 | 2 | 3 | 3 | 0 | 3 | 1 | 0 | 1 | 2 | 0 | 0 | 2 | 0 | 0 | 0 | 0 | 2 | 0 |
| Peroxisomes | 0 | 0 | 0 | 0 | 0 | 0 | 0 | 0 | 0 | 0 | 0 | 0 | 0 | 0 | 0 | 0 | 0 | 0 | 0 | 0 | 0 | 0 | 0 | 0 |
| SpindlePole | 1 | 0 | 3 | 1 | 0 | 4 | 5 | 2 | 7 | 1 | 3 | 7 | 1 | 0 | 1 | 0 | 0 | 1 | 5 | 3 | 10 | 2 | 10 | 9 |
| Vac/Vac Membrane | 0 | 7 | 2 | 0 | 14 | 16 | 17 | 9 | 6 | 8 | 6 | 7 | 2 | 5 | 1 | 61 | 45 | 38 | 2 | 9 | 3 | 3 | 4 | 3 |
| Unique Cell Count | 138 | 101 | 244 | 256 | 323 | 346 | 435 | 364 | 309 | 310 | 252 | 255 | 235 | 322 | 383 | 170 | 140 | 117 | 146 | 125 | 234 | 170 | 295 | 265 |
| Labelled Cell Count | 153 | 104 | 249 | 268 | 334 | 393 | 529 | 428 | 409 | 368 | 321 | 318 | 238 | 325 | 386 | 197 | 154 | 128 | 146 | 125 | 234 | 170 | 295 | 265 |
Yeast GFP Assignment
Protein Abundance
| Screen | WT1 | WT2 | WT3 | RAP60 | RAP140 | RAP220 | RAP300 | RAP380 | RAP460 | RAP540 | RAP620 | RAP700 | HU80 | HU120 | HU160 | rpd3Δ_1 | rpd3Δ_2 | rpd3Δ_3 | AF100 | AF140 | AF180 |
|---|---|---|---|---|---|---|---|---|---|---|---|---|---|---|---|---|---|---|---|---|---|
| Mean Cell GFP Intensity (1e-4) | 2.9 | 4.8 | 4.5 | 4.1 | 4.6 | 3.9 | 3.5 | 4.0 | 3.3 | 3.6 | 3.2 | 3.5 | 5.2 | 4.8 | 5.1 | 9.6 | 9.0 | 9.4 | 4.3 | 5.2 | 5.6 |
| Std Deviation (1e-4) | 0.3 | 1.3 | 1.3 | 1.2 | 1.8 | 1.7 | 1.4 | 1.3 | 1.5 | 1.9 | 1.2 | 1.3 | 9.8 | 1.6 | 1.9 | 2.3 | 2.4 | 5.7 | 1.2 | 2.6 | 2.4 |
| Intensity Change (Log2) | – | – | – | -0.15 | 0.05 | -0.22 | -0.35 | -0.17 | -0.44 | -0.33 | -0.5 | -0.34 | 0.22 | 0.11 | 0.17 | 1.09 | 0.99 | 1.06 | -0.07 | 0.2 | 0.31 |
Localization Change
| Localization | RAP60 | RAP140 | RAP220 | RAP300 | RAP380 | RAP460 | RAP540 | RAP620 | RAP700 | HU80 | HU120 | HU160 | rpd3Δ_1 | rpd3Δ_2 | rpd3Δ_3 |
|---|---|---|---|---|---|---|---|---|---|---|---|---|---|---|---|
| Actin | – | – | – | – | – | – | – | – | – | – | – | – | – | – | – |
| Bud | – | – | – | – | – | – | – | – | – | – | – | – | 0 | 0 | 0 |
| Bud Neck | – | – | – | – | – | – | – | – | – | – | – | – | 0 | 0 | 0 |
| Bud Site | – | – | – | – | – | – | – | – | – | – | – | – | 0 | 0 | 0 |
| Cell Periphery | – | – | – | – | – | – | – | – | – | – | – | – | 0 | 0 | 0 |
| Cyto | – | – | – | – | – | – | – | – | – | – | – | – | – | – | – |
| Endoplasmic Reticulum | – | – | – | – | – | – | – | – | – | – | – | – | 0 | 0 | 0 |
| Endosome | – | – | – | – | – | – | – | – | – | – | – | – | 0 | 0 | 0 |
| Golgi | – | – | – | – | – | – | – | – | – | – | – | – | 0 | 0 | 0 |
| Mitochondria | – | – | – | – | – | – | – | – | – | – | – | – | 0 | 0 | 0 |
| Nuclear Periphery | – | – | – | – | – | – | – | – | – | – | – | – | 0 | 0 | 0 |
| Nuc | – | – | – | – | – | – | – | – | – | – | – | – | – | – | – |
| Nucleolus | – | – | – | – | – | – | – | – | – | – | – | – | 0 | 0 | 0 |
| Peroxisomes | – | – | – | – | – | – | – | – | – | – | – | – | 0 | 0 | 0 |
| SpindlePole | – | – | – | – | – | – | – | – | – | – | – | – | 0 | 0 | 0 |
| Vac | – | – | – | – | – | – | – | – | – | – | – | – | – | – | – |
| Cortical Patches | – | – | – | – | – | – | – | – | – | – | – | – | 0 | 0 | 0 |
| Cytoplasm | – | – | – | – | – | – | – | – | – | – | – | – | 0 | 0 | 0 |
| Nucleus | – | – | – | – | – | – | – | – | – | – | – | – | 0 | 0 | 0 |
| Vacuole | – | – | – | – | – | – | – | – | – | – | – | – | 9.8 | 9.0 | 9.0 |
External localization resources
Images






























Protein Concentration and Protein Localization Data
| R1 | R2 | R3 | ||||||||||||||||
|---|---|---|---|---|---|---|---|---|---|---|---|---|---|---|---|---|---|---|
| G1 Pre-START | G1 Post-START | S/G2 | Metaphase | Anaphase | Telophase | G1 Pre-START | G1 Post-START | S/G2 | Metaphase | Anaphase | Telophase | G1 Pre-START | G1 Post-START | S/G2 | Metaphase | Anaphase | Telophase | |
| Concentration | -1.1043 | -0.6308 | -1.0132 | -1.1344 | -1.434 | -0.6366 | -0.2402 | -0.4565 | -0.5673 | -0.3976 | -0.8417 | -0.439 | -1.1257 | -0.8208 | -0.8153 | -0.704 | -0.9499 | -0.9137 |
| Actin | 0.0025 | 0.0006 | 0.0003 | 0.0005 | 0.0003 | 0.0035 | 0.0474 | 0.0002 | 0.0115 | 0.0177 | 0.0005 | 0.0087 | 0.0132 | 0.0012 | 0.012 | 0.0003 | 0.0415 | 0.0015 |
| Bud | 0.0041 | 0.0024 | 0.0004 | 0.0002 | 0.0001 | 0.0036 | 0.0016 | 0.0002 | 0.0015 | 0.0005 | 0.0211 | 0.0004 | 0.0009 | 0.0015 | 0.0029 | 0 | 0.0114 | 0.0005 |
| Bud Neck | 0.0008 | 0.0014 | 0.0003 | 0.0003 | 0.0004 | 0.0028 | 0.0043 | 0.0002 | 0.001 | 0.0196 | 0.0002 | 0.0014 | 0.0006 | 0.0004 | 0.0015 | 0.0002 | 0.0012 | 0.0039 |
| Bud Periphery | 0.0023 | 0.0007 | 0.0006 | 0.0002 | 0.0001 | 0.0013 | 0.0027 | 0.0002 | 0.0023 | 0.0009 | 0.0053 | 0.0007 | 0.0008 | 0.0013 | 0.0026 | 0 | 0.0026 | 0.0005 |
| Bud Site | 0.0011 | 0.0144 | 0.0004 | 0.0002 | 0.0001 | 0.0003 | 0.0052 | 0.0017 | 0.0018 | 0.002 | 0.0003 | 0.0008 | 0.0012 | 0.0049 | 0.0041 | 0.0001 | 0.0006 | 0.0022 |
| Cell Periphery | 0.0002 | 0.0002 | 0 | 0 | 0 | 0.0001 | 0.0006 | 0.0002 | 0.0002 | 0.0004 | 0.0001 | 0.0001 | 0.0001 | 0.0002 | 0.0003 | 0 | 0.0002 | 0.0001 |
| Cytoplasm | 0.1149 | 0.1282 | 0.0777 | 0.0837 | 0.078 | 0.1267 | 0.0979 | 0.1136 | 0.1055 | 0.065 | 0.0998 | 0.1649 | 0.1804 | 0.2363 | 0.14 | 0.2218 | 0.1554 | 0.2258 |
| Cytoplasmic Foci | 0.0138 | 0.0092 | 0.0072 | 0.0032 | 0.0096 | 0.0147 | 0.0458 | 0.013 | 0.0204 | 0.049 | 0.0031 | 0.011 | 0.0123 | 0.0184 | 0.0156 | 0.004 | 0.0063 | 0.014 |
| Eisosomes | 0.0002 | 0.0001 | 0.0001 | 0.0002 | 0.0007 | 0.0001 | 0.0009 | 0.0001 | 0.0002 | 0.0001 | 0 | 0.0001 | 0.0002 | 0.0001 | 0.0002 | 0 | 0.0005 | 0.0001 |
| Endoplasmic Reticulum | 0.0023 | 0.0021 | 0.0017 | 0.0006 | 0.001 | 0.0037 | 0.0028 | 0.0015 | 0.0028 | 0.0033 | 0.0015 | 0.0027 | 0.004 | 0.0027 | 0.0034 | 0.0011 | 0.0014 | 0.0023 |
| Endosome | 0.0057 | 0.0033 | 0.0028 | 0.0006 | 0.0024 | 0.009 | 0.0203 | 0.0014 | 0.0058 | 0.0219 | 0.0012 | 0.0044 | 0.0068 | 0.0043 | 0.0061 | 0.0009 | 0.002 | 0.0052 |
| Golgi | 0.0006 | 0.0002 | 0.0001 | 0 | 0.0001 | 0.0007 | 0.0067 | 0.0001 | 0.0006 | 0.0089 | 0 | 0.0012 | 0.0011 | 0.0002 | 0.0013 | 0 | 0.0008 | 0.0003 |
| Lipid Particles | 0.002 | 0.0004 | 0.0005 | 0.0002 | 0.0007 | 0.0042 | 0.0209 | 0.0008 | 0.002 | 0.0043 | 0.0001 | 0.0006 | 0.002 | 0.0006 | 0.0032 | 0 | 0.0006 | 0.0005 |
| Mitochondria | 0.0012 | 0.0007 | 0.001 | 0.0007 | 0.0003 | 0.0011 | 0.0037 | 0.0005 | 0.0022 | 0.0041 | 0.0007 | 0.0008 | 0.0016 | 0.0017 | 0.0054 | 0.0006 | 0.0007 | 0.0019 |
| None | 0.6949 | 0.6768 | 0.7486 | 0.7731 | 0.7365 | 0.6461 | 0.6153 | 0.8183 | 0.7594 | 0.7206 | 0.7228 | 0.7283 | 0.6183 | 0.5903 | 0.6149 | 0.5835 | 0.6348 | 0.5663 |
| Nuclear Periphery | 0.0063 | 0.0072 | 0.0136 | 0.0027 | 0.0037 | 0.0097 | 0.0052 | 0.0027 | 0.0058 | 0.0054 | 0.0057 | 0.0049 | 0.0116 | 0.0052 | 0.0083 | 0.0029 | 0.0044 | 0.0079 |
| Nucleolus | 0.0042 | 0.002 | 0.0024 | 0.0011 | 0.0023 | 0.0023 | 0.0029 | 0.0006 | 0.0021 | 0.0022 | 0.0008 | 0.0007 | 0.0024 | 0.002 | 0.0046 | 0.0007 | 0.0012 | 0.0017 |
| Nucleus | 0.1211 | 0.1351 | 0.1218 | 0.1246 | 0.1249 | 0.1306 | 0.0764 | 0.0381 | 0.0607 | 0.0466 | 0.1317 | 0.0576 | 0.1201 | 0.1147 | 0.1427 | 0.1802 | 0.1048 | 0.1339 |
| Peroxisomes | 0.0017 | 0.0003 | 0.0004 | 0.0002 | 0.0002 | 0.0009 | 0.0153 | 0.0006 | 0.0018 | 0.014 | 0.0001 | 0.0006 | 0.0028 | 0.0005 | 0.0028 | 0.0001 | 0.0004 | 0.0005 |
| Punctate Nuclear | 0.0144 | 0.0124 | 0.018 | 0.0069 | 0.0377 | 0.0369 | 0.0209 | 0.0043 | 0.008 | 0.0067 | 0.0034 | 0.008 | 0.0149 | 0.0101 | 0.024 | 0.003 | 0.0278 | 0.0287 |
| Vacuole | 0.0049 | 0.002 | 0.0015 | 0.0007 | 0.0007 | 0.0013 | 0.0026 | 0.0014 | 0.0037 | 0.0052 | 0.0012 | 0.0017 | 0.0042 | 0.003 | 0.0033 | 0.0005 | 0.0012 | 0.0017 |
| Vacuole Periphery | 0.0007 | 0.0003 | 0.0005 | 0.0002 | 0.0002 | 0.0004 | 0.0007 | 0.0002 | 0.0007 | 0.0014 | 0.0003 | 0.0004 | 0.0007 | 0.0004 | 0.0008 | 0.0001 | 0.0003 | 0.0005 |
Sequencing Data
| R1 | R2 | |||||||||
|---|---|---|---|---|---|---|---|---|---|---|
| G1 Post-START | S/G2 | Metaphase | Anaphase | Telophase | G1 Post-START | S/G2 | Metaphase | Anaphase | Telophase | |
| Gene Expression | 2.1699 | 0.9699 | 6.4773 | 7.0181 | 2.8134 | 7.5905 | 5.8839 | 8.2734 | 8.1191 | 5.3067 |
| Translational Efficiency | – | – | – | – | – | – | – | – | – | – |
Hit Data
| Dataset | Hit |
|---|---|
| Protein Concentration | ✘ |
| Protein Localization | ✘ |
| Gene Expression | ✘ |
| Translational Efficiency | – |
Micrographs
































Cell Count
| R1 | R2 | R1 & R2 | |||||||||
|---|---|---|---|---|---|---|---|---|---|---|---|
| WT | UBP2 | UBP14 | UBP2UBP14 | WT | UBP2 | UBP14 | UBP2UBP14 | WT | UBP2 | UBP14 | UBP2UBP14 |
| 1505 | 653 | 2816 | 81 | 2343 | 2139 | 1491 | 1496 | 3848 | 2792 | 4307 | 1577 |
Protein Abundance
| R1 | R2 | R1 & R2 | ||||||||||
|---|---|---|---|---|---|---|---|---|---|---|---|---|
| WT | UBP2 | UBP14 | UBP2UBP14 | WT | UBP2 | UBP14 | UBP2UBP14 | WT | UBP2 | UBP14 | UBP2UBP14 | |
| Mean | 617.97 | 638.80 | 782.70 | 835.82 | 627.79 | 698.75 | 796.79 | 817.90 | 623.95 | 684.73 | 787.58 | 818.82 |
| Standard Deviation | 65.16 | 94.86 | 88.94 | 122.80 | 74.71 | 79.73 | 93.25 | 115.34 | 71.29 | 87.29 | 90.70 | 115.80 |
| Intensity Change Log 2 | — | 0.047828 | 0.340923 | 0.435655 | — | 0.154494 | 0.343917 | 0.381642 | — | 0.102567 | 0.342433 | 0.408689 |
Localization Score (DeepLoc)
| R1 | R2 | R1 & R2 | ||||||||||
|---|---|---|---|---|---|---|---|---|---|---|---|---|
| WT | UBP2 | UBP14 | UBP2UBP14 | WT | UBP2 | UBP14 | UBP2UBP14 | WT | UBP2 | UBP14 | UBP2UBP14 | |
| Actin | 0.000132 | 0.000382 | 0.000100 | 0.000299 | 0.000094 | 0.000330 | 0.000059 | 0.002613 | 0.000109 | 0.000342 | 0.000086 | 0.002494 |
| Bud Neck | 0.029434 | 0.036670 | 0.005952 | 0.001578 | 0.020751 | 0.038399 | 0.002161 | 0.015873 | 0.024147 | 0.037995 | 0.004640 | 0.015139 |
| Bud Site | 0.003286 | 0.014410 | 0.009198 | 0.004542 | 0.004113 | 0.015591 | 0.001934 | 0.059314 | 0.003789 | 0.015315 | 0.006683 | 0.056500 |
| Cell Periphery | 0.000194 | 0.000167 | 0.000099 | 0.000295 | 0.000106 | 0.000174 | 0.000194 | 0.000271 | 0.000140 | 0.000173 | 0.000132 | 0.000272 |
| Cytoplasm | 0.377224* | 0.289215* | 0.242646* | 0.318767* | 0.445278* | 0.413454* | 0.321236* | 0.433192* | 0.418661* | 0.384396* | 0.269853* | 0.427315* |
| Cytoplasmic Foci | 0.317584* | 0.282863* | 0.002413 | 0.063213 | 0.189574* | 0.229668* | 0.017243 | 0.014625 | 0.239640* | 0.242109* | 0.007546 | 0.017121 |
| Eisosomes | 0.000332 | 0.000183 | 0.000012 | 0.000140 | 0.000152 | 0.000147 | 0.000051 | 0.000040 | 0.000222 | 0.000155 | 0.000026 | 0.000045 |
| Endoplasmic Reticulum | 0.000698 | 0.001156 | 0.001182 | 0.003917 | 0.001759 | 0.000530 | 0.000887 | 0.001793 | 0.001344 | 0.000677 | 0.001080 | 0.001902 |
| Endosome | 0.015893 | 0.029414 | 0.000541 | 0.006624 | 0.008725 | 0.015474 | 0.001561 | 0.006395 | 0.011529 | 0.018734 | 0.000894 | 0.006407 |
| Golgi | 0.004586 | 0.005206 | 0.000034 | 0.015761 | 0.002428 | 0.004399 | 0.000374 | 0.003020 | 0.003272 | 0.004587 | 0.000152 | 0.003674 |
| Lipid Particles | 0.022439 | 0.018247 | 0.000304 | 0.004375 | 0.014050 | 0.008745 | 0.001170 | 0.000917 | 0.017331 | 0.010967 | 0.000604 | 0.001095 |
| Mitochondria | 0.014248 | 0.022771 | 0.000855 | 0.005647 | 0.007244 | 0.011679 | 0.000440 | 0.004531 | 0.009984 | 0.014273 | 0.000711 | 0.004589 |
| Mitotic Spindle | 0.001023 | 0.003264 | 0.002360 | 0.003440 | 0.001354 | 0.009075 | 0.001177 | 0.036418 | 0.001225 | 0.007716 | 0.001951 | 0.034724 |
| None | 0.003772 | 0.006821 | 0.003885 | 0.003729 | 0.003950 | 0.003795 | 0.010950 | 0.006861 | 0.003880 | 0.004503 | 0.006331 | 0.006700 |
| Nuclear Periphery | 0.000474 | 0.001115 | 0.001523 | 0.001686 | 0.000585 | 0.000432 | 0.000942 | 0.001608 | 0.000542 | 0.000592 | 0.001322 | 0.001612 |
| Nuclear Periphery Foci | 0.000306 | 0.000823 | 0.000124 | 0.001984 | 0.000261 | 0.000306 | 0.000269 | 0.001405 | 0.000279 | 0.000427 | 0.000175 | 0.001434 |
| Nucleolus | 0.001607 | 0.004826 | 0.000301 | 0.000763 | 0.001642 | 0.001802 | 0.000746 | 0.000790 | 0.001628 | 0.002509 | 0.000455 | 0.000788 |
| Nucleus | 0.156631* | 0.183146* | 0.717678* | 0.396879* | 0.251039* | 0.178976* | 0.614043* | 0.326778* | 0.214115* | 0.179952* | 0.681801* | 0.330378* |
| Peroxisomes | 0.016117 | 0.033923 | 0.000130 | 0.000574 | 0.004912 | 0.017194 | 0.000394 | 0.002120 | 0.009294 | 0.021107 | 0.000222 | 0.002041 |
| Vacuole | 0.032873 | 0.062180 | 0.010535 | 0.162351 | 0.041117 | 0.048317 | 0.024048 | 0.078410 | 0.037893 | 0.051560 | 0.015213 | 0.082721 |
| Vacuole Periphery | 0.001149 | 0.003217 | 0.000126 | 0.003437 | 0.000867 | 0.001512 | 0.000121 | 0.003027 | 0.000977 | 0.001911 | 0.000125 | 0.003048 |
Localization Changes (T-score)
| R1 | R2 | R1 & R2 | |||||||||||||
|---|---|---|---|---|---|---|---|---|---|---|---|---|---|---|---|
| UBP2_WT | UBP14_WT | UBP2UBP14_WT | UBP2UBP14_UBP2 | UBP2UBP14_UBP14 | UBP2_WT | UBP14_WT | UBP2UBP14_WT | UBP2UBP14_UBP2 | UBP2UBP14_UBP14 | UBP2_WT | UBP14_WT | UBP2UBP14_WT | UBP2UBP14_UBP2 | UBP2UBP14_UBP14 | |
| Actin | -5.87 | 0.31 | -2.88 | 0.10 | -2.96 | -5.50 | 1.78 | -2.14 | -1.73 | -2.17 | -6.84 | 0.05 | -2.14 | -1.71 | -2.14 |
| Bud Neck | -1.68 | 10.64 | 12.46 | 9.86 | 4.05 | -7.27 | 13.34 | 5.51 | 11.67 | -8.05 | -6.57 | 15.69 | 8.63 | 13.27 | -5.69 |
| Bud Site | -5.30 | -4.32 | -0.76 | 3.18 | 1.66 | -7.74 | 3.11 | -9.04 | -4.87 | -9.76 | -9.41 | -3.03 | -9.21 | -4.91 | -8.00 |
| Cell Periphery | 1.52 | 6.41 | -0.80 | -1.26 | -2.46 | -5.92 | -5.15 | -1.92 | -0.13 | -0.06 | -3.10 | 1.64 | -1.16 | -0.28 | -1.55 |
| Cytoplasm | 7.50 | 18.44 | 4.48 | 0.90 | -1.25 | 4.12 | 16.69 | 11.11 | 6.93 | -4.84 | 5.34 | 29.24 | 9.40 | 4.47 | -11.73 |
| Cytoplasmic Foci | 2.85 | 53.08 | 25.84 | 19.28 | -4.72 | -6.39 | 40.84 | 42.88 | 45.01 | 3.42 | -0.66 | 65.08 | 61.99 | 52.89 | -5.89 |
| Eisosomes | 6.39 | 16.10 | 7.25 | 1.64 | -9.02 | 0.46 | 14.03 | 14.35 | 16.01 | 0.08 | 6.48 | 21.89 | 18.17 | 17.68 | -14.22 |
| Endoplasmic Reticulum | -3.10 | -7.24 | -4.27 | -3.84 | -3.46 | 4.57 | 1.62 | -4.57 | -16.91 | -11.07 | 3.87 | -1.03 | -8.61 | -16.18 | -10.23 |
| Endosome | -4.88 | 13.96 | 6.97 | 8.73 | -5.42 | -6.50 | 11.96 | 6.41 | 11.22 | -2.73 | -6.81 | 19.19 | 9.87 | 14.06 | -4.35 |
| Golgi | -0.52 | 9.10 | -0.32 | -0.25 | -1.01 | -3.70 | 7.56 | 1.94 | 4.12 | -1.41 | -2.67 | 12.92 | 2.55 | 3.92 | -2.02 |
| Lipid Particles | 1.72 | 15.56 | 12.18 | 7.03 | -7.72 | 4.70 | 13.75 | 13.80 | 12.24 | 0.32 | 6.10 | 20.95 | 20.04 | 14.55 | -10.88 |
| Mitochondria | -2.37 | 8.43 | 4.21 | 5.28 | -0.73 | -3.60 | 8.33 | 5.00 | 8.95 | -4.71 | -3.26 | 11.60 | 8.12 | 10.73 | -4.10 |
| Mitotic Spindle | -2.03 | -2.34 | -1.22 | -0.06 | -0.27 | -5.16 | -0.07 | -8.30 | -4.72 | -8.15 | -5.58 | -2.05 | -8.44 | -5.29 | -7.86 |
| None | -1.72 | -0.12 | 1.03 | 2.27 | 1.41 | 0.28 | -4.19 | -1.78 | -1.99 | 3.04 | -0.79 | -3.11 | -1.94 | -0.98 | 0.74 |
| Nuclear Periphery | -2.69 | -18.29 | -6.16 | -3.14 | -1.47 | 3.16 | -11.17 | -20.17 | -22.12 | -14.66 | -0.74 | -22.57 | -21.51 | -18.99 | -11.07 |
| Nuclear Periphery Foci | -2.58 | 1.41 | -4.71 | -3.37 | -5.05 | -0.91 | -2.55 | -3.58 | -3.38 | -3.11 | -2.34 | 0.76 | -3.95 | -3.30 | -4.10 |
| Nucleolus | -4.68 | 6.21 | 2.25 | 5.58 | -1.66 | -0.31 | 3.47 | 3.49 | 6.19 | 0.39 | -3.14 | 6.31 | 4.80 | 8.47 | -2.12 |
| Nucleus | -2.63 | -86.66* | -8.38 | -7.16 | 12.22 | 11.85 | -43.93 | -16.14 | -24.54 | 22.68 | 6.78 | -90.58 | -22.34 | -25.68 | 36.76 |
| Peroxisomes | -5.06 | 14.74 | 14.34 | 9.95 | -4.17 | -10.19 | 11.25 | 8.58 | 13.90 | -1.87 | -9.19 | 18.43 | 15.14 | 16.69 | -2.65 |
| Vacuole | -7.46 | 11.42 | -7.93 | -6.80 | -8.57 | -3.25 | 1.58 | -20.06 | -18.57 | -19.97 | -7.40 | 11.01 | -22.08 | -19.19 | -24.76 |
| Vacuole Periphery | -5.58 | 11.15 | -0.30 | 1.08 | -1.05 | -4.63 | 11.50 | -1.04 | 0.64 | -3.08 | -6.73 | 15.90 | -0.82 | 1.60 | -3.22 |
Endocytosis
| Temp | Actin Patch (Sac6-tdTomato) | Cortical Patch (Sla1-GFP) | Late Endosome (Snf7-GFP) | Vacuole (Vph1-GFP) |
|---|---|---|---|---|
| 37℃ | ||||
| RT |
Cell Cycle Omics
CYCLoPs (Mho1-GFP)
| Gene / Allele | Actin Patch (Sac6-tdTomato) | Cortical Patch (Sla1-GFP) | Late Endosome (Snf7-GFP) | Vacuole (Sac6-tdTomato) |
|---|
| Gene | Images |
|---|
| Gene | Images |
|---|
Images are not yet available
Images are not yet available